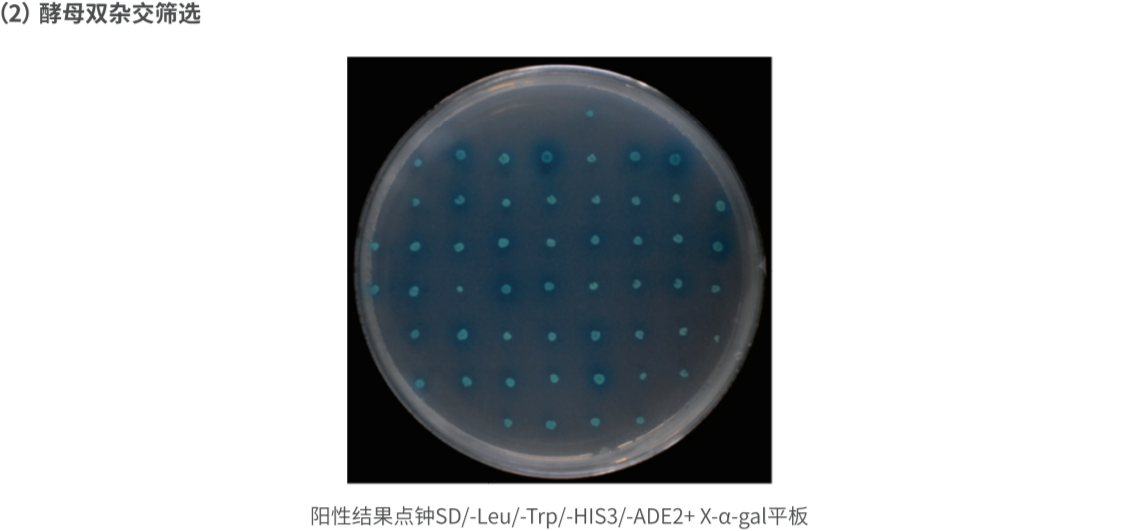

公司党总支携手省临床检验中心党委举办“七一党联体”主题党日活动
7月1日,武汉生之源生物科技股份有限公司党总支与湖北省临床检验中心党委在高科医疗器械园共同举办了七一党联体主题党日活动。此次活动
05
2023.09酵母单杂质粒和双杂质粒的区别是什么?
在酵母细胞中,单杂质粒和双杂质粒是两种常见的质粒构建方式,它们之间的区别主要体现在dna序列的组成和功能特点上。 单杂质粒(sin ......

05
2023.09ihc-p和ihc区别
ihc-p(immunohistochemistry-paraffin)和ihc(immunohistochemistry)是两种常用的免疫组化技术,用于检测组织切片中特定抗原的表达 ......

04
2023.09biacore与表面等离子共振spr的区别
biacore和表面等离子共振(surface plasmon resonance,spr)是两种常见的生物传感技术,用于研究分子间的相互作用。它们之间的主要 ......

04
2023.09酵母杂交实验常见问题有哪些?
酵母杂交实验是一种用于研究蛋白质相互作用和功能的常见方法。在进行酵母杂交实验时,可能会遇到以下一些常见问题: 负荷过大:酵母 ......

04
2023.09磁珠法提取dna的原理及注意事项
磁珠法是常用的dna提取方法,其原理基于磁性珠子(通常是硅胶或磁性粒子)对dna的亲和力。下面是磁珠法提取dna的主要原理和注意事项: ......

须知
首次微信扫码用户步骤:
1.微信扫码。
2.本页面完善手机验证。


扫码领资料

电话:027-87960366

